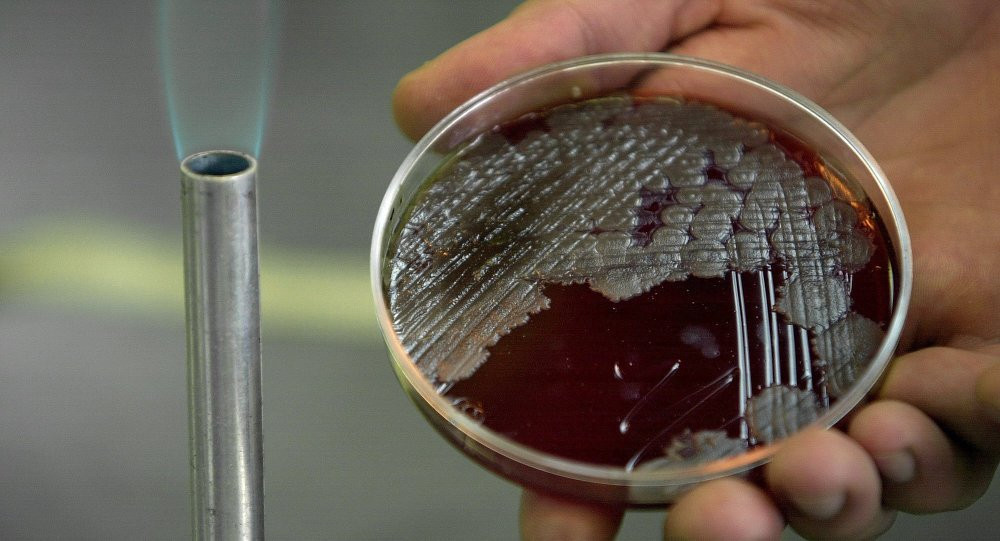
vi-khuan-benh-than-1

Channel A News dẫn nguồn tin tình báo Hàn Quốc tiết lộ rằng kháng thể bệnh than được tìm thấy trong cơ thể binh sỹ Triều Tiên đào tẩu sang Hàn Quốc năm 2017.
Dù vậy, vẫn chưa rõ binh sỹ này bị phơi nhiễm hay bị tiêm kháng sinh chống bệnh than và nguồn tin nói trên không nói rõ đó là binh sỹ nào trong số 4 binh sỹ bỏ trốn từ Triều Tiên sang Hàn Quốc. Theo Sputnik, năm 2017 có 4 binh sỹ Triều Tiên đào tẩu vào các ngày 12/6, 18/6, 13/11 và 20/12.
Theo đó, binh sỹ mang kháng thể bệnh than này hình thành kháng thể từ trước khi đào tẩu. Tin tức làm dấy lên lo ngại về loại bệnh có thể giết chết ước tính 80% người bị lây nhiễm, theo UPI.
Mẫu vi khuẩn bệnh than. (Ảnh: AP)
Bộ trưởng Quốc phòng Hàn Quốc Choi Hyun-soo cho biết, Seoul chưa có vaccine bệnh than và dự kiến phải đến cuối năm 2019 mới phát triển được vaccine cho quân đội.
Trước đó, tờ báo Nhật Asahi đưa tin Triều Tiên bắt đầu thử nghiệm gắn vi khuẩn bệnh than lên trên đầu đạn của các tên lửa đạn đạo liên lục địa. Asahi cũng dẫn một nguồn tin tình báo cho biết Triều Tiên thực hiện các thử nghiệm về khả năng chịu nhiệt và áp lực để xem các mẫu vi khuẩn có thể sống sót ở nhiệt độ trên 7.000 độ C khi tên lửa tái nhập khí quyển Trái Đất hay không.
Dù Triều Tiên hoàn toàn phủ nhận thông tin này, Tổng thống Mỹ Donald Trump vẫn đáp lại trong báo cáo Chiến lược An ninh Quốc gia ngày 19/12 rằng chính quyền Kim Jong-un đang theo đuổi vũ khí hóa sinh có khả năng được vận chuyển bằng tên lửa.
Video: Nghi vấn Triều Tiên chế thuốc làm từ vàng

Bình luận